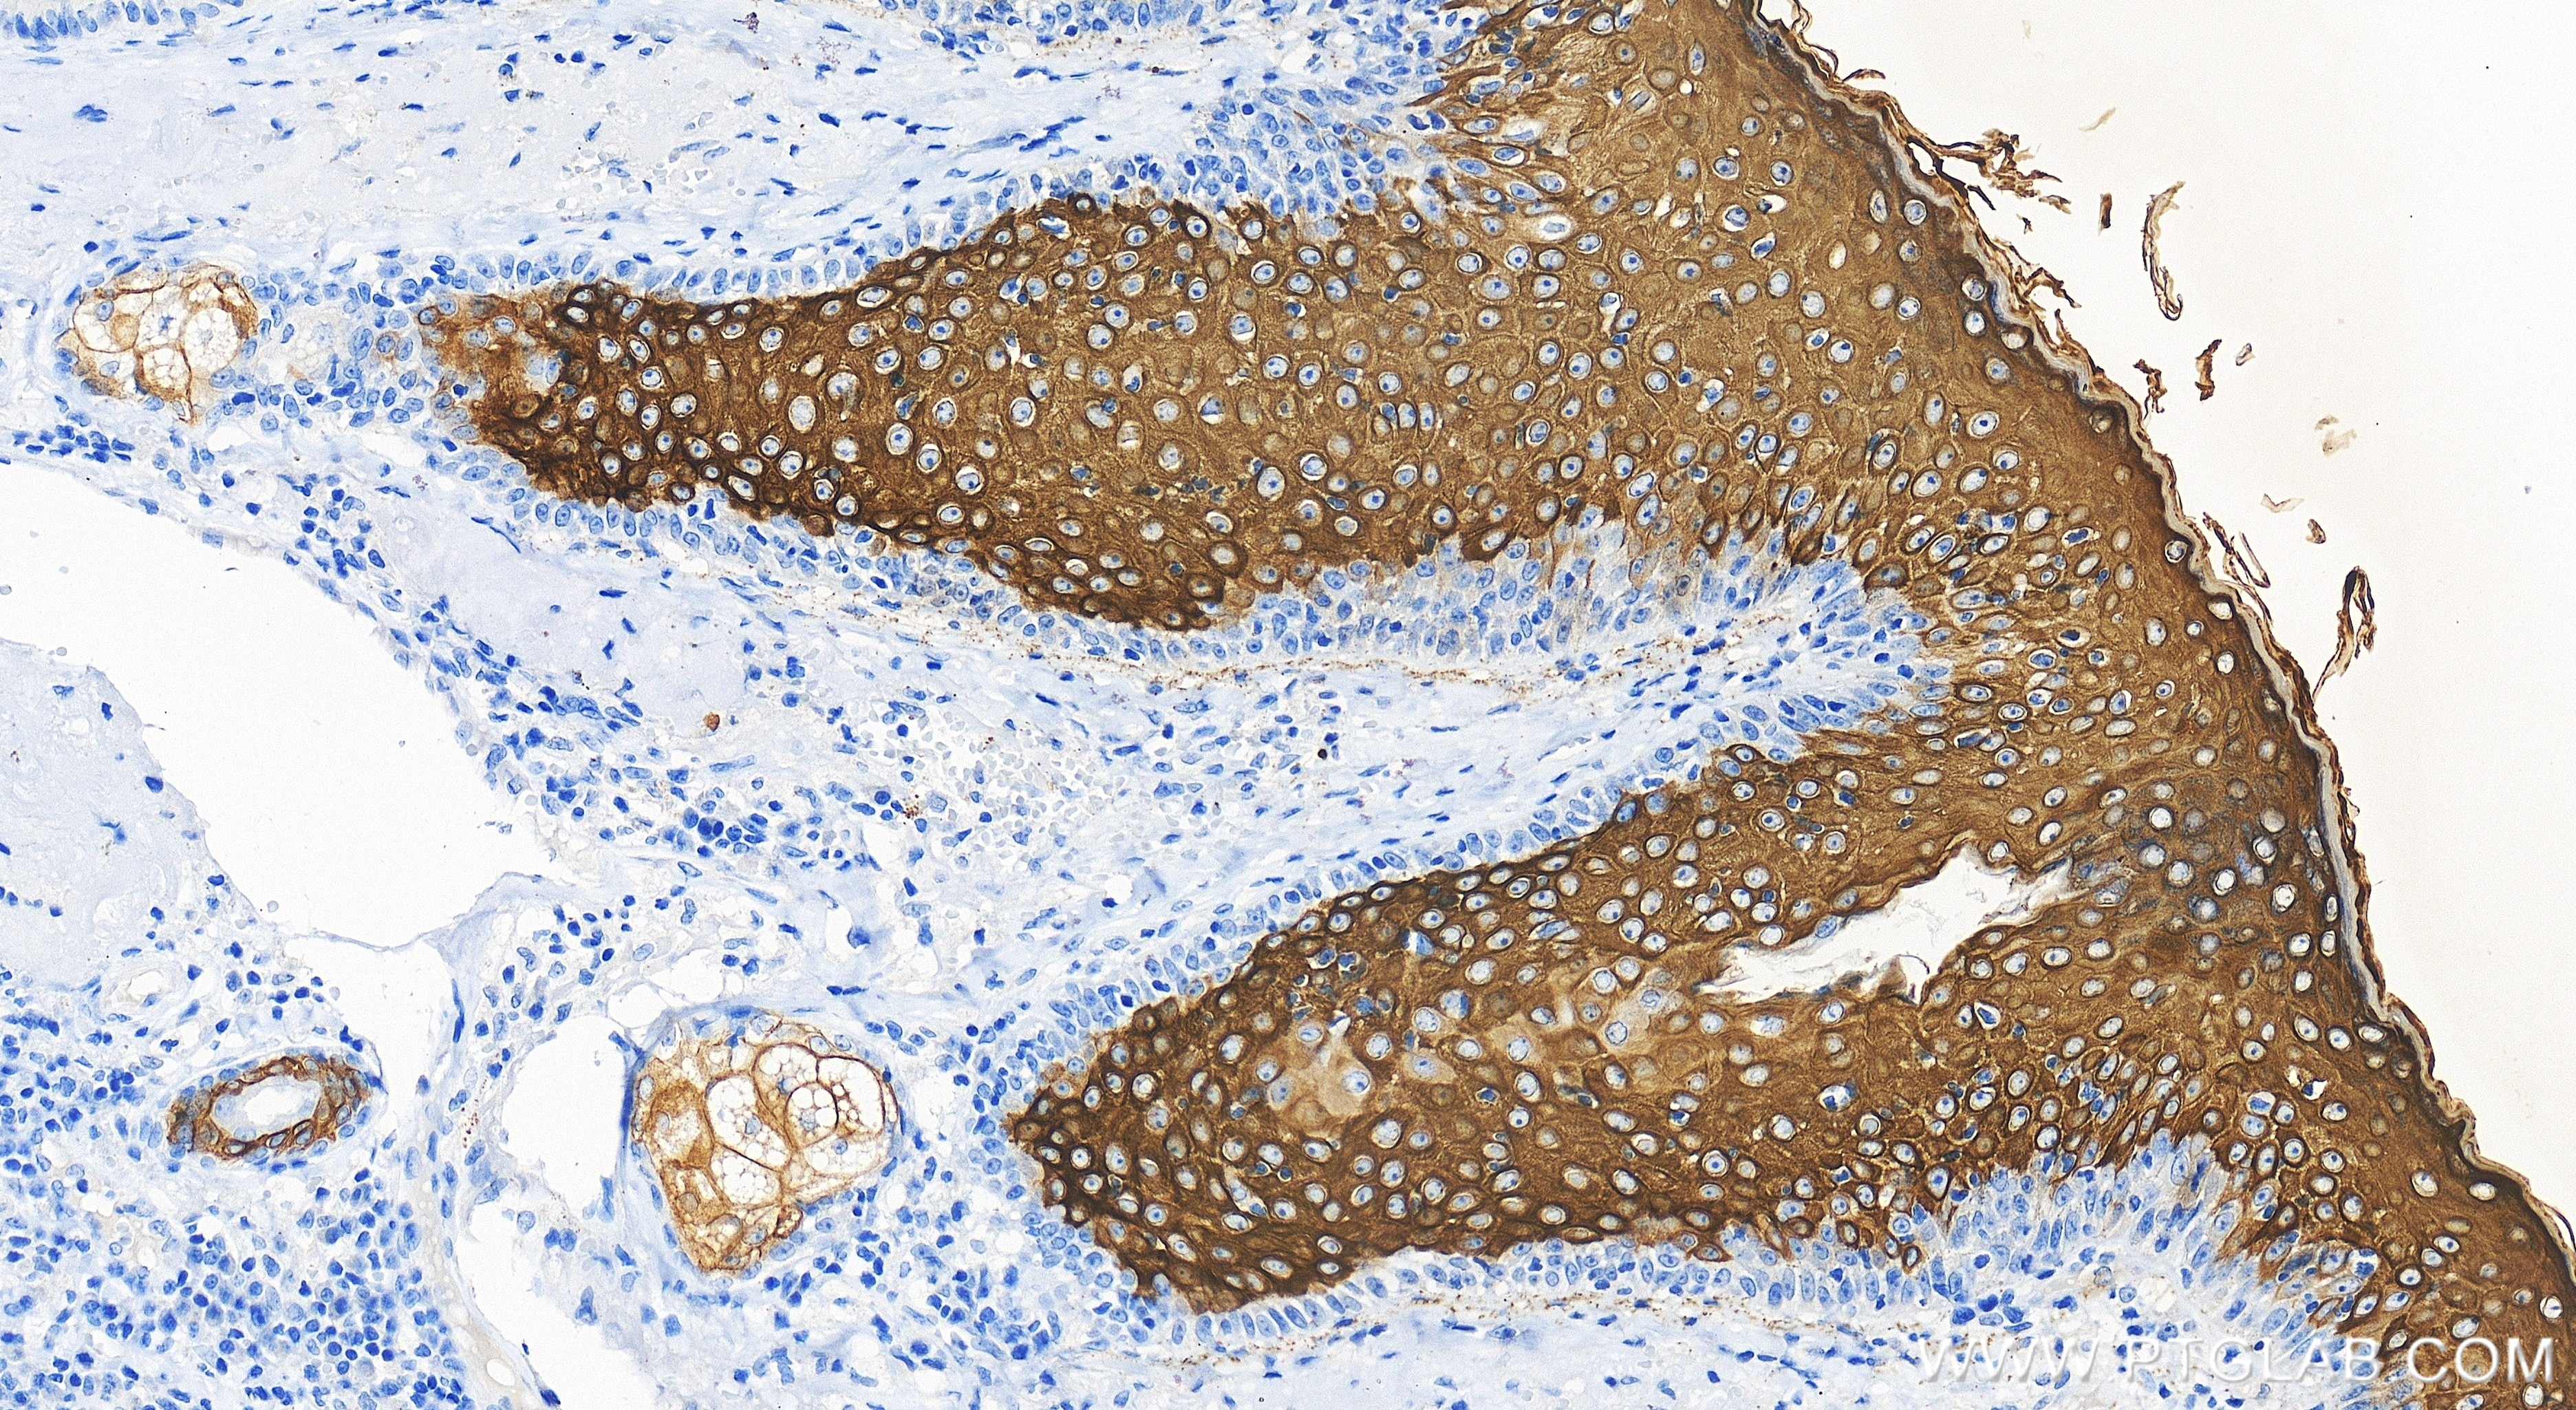
Immunohistochemistry (IHC) staining of human skin cancer tissue using Cytokeratin 10 Recombinant antibody (86324-1-RR)

Tested Applications
| Positive WB detected in | mouse skin tissue, rat skin tissue |
| Positive IHC detected in | human skin cancer tissue Note: suggested antigen retrieval with TE buffer pH 9.0; (*) Alternatively, antigen retrieval may be performed with citrate buffer pH 6.0 |
| Positive IF-P detected in | mouse skin tissue |
Recommended dilution
| Application | Dilution |
|---|---|
| Western Blot (WB) | WB : 1:5000-1:50000 |
| Immunohistochemistry (IHC) | IHC : 1:500-1:2000 |
| Immunofluorescence (IF)-P | IF-P : 1:50-1:500 |
| It is recommended that this reagent should be titrated in each testing system to obtain optimal results. | |
| Sample-dependent, Check data in validation data gallery. | |
Product Information
86324-1-RR targets Cytokeratin 10 in WB, IHC, IF-P, ELISA applications and shows reactivity with human, mouse, rat samples.
| Tested Reactivity | human, mouse, rat |
| Host / Isotype | Rabbit / IgG |
| Class | Recombinant |
| Type | Antibody |
| Immunogen |
Peptide Predict reactive species |
| Full Name | keratin 10 |
| Calculated Molecular Weight | 584 aa, 59 kDa |
| Observed Molecular Weight | 59 kDa |
| GenBank Accession Number | BC034697 |
| Gene Symbol | Cytokeratin 10 |
| Gene ID (NCBI) | 3858 |
| Conjugate | Unconjugated |
| Form | Liquid |
| Purification Method | Protein A purification |
| UNIPROT ID | P13645 |
| Storage Buffer | PBS with 0.02% sodium azide and 50% glycerol, pH 7.3. |
| Storage Conditions | Store at -20°C. Stable for one year after shipment. Aliquoting is unnecessary for -20oC storage. 20ul sizes contain 0.1% BSA. |
Background Information
Cytokeratin 10 (CK-10, K10, KRT10) is a type I (acidic) cytokeratin and part of the intermediate filament protein superfamily. It is expressed in keratinized stratified epithelium, suprabasal cell layers (including the stratum corneum), and differentiated areas of highly differentiated squamous cell carcinomas. CK-10 plays a role in maintaining the structural integrity of epithelial cells and is involved in differentiation, tissue specialization, and epidermal barrier establishment. Mutations in the KRT10 gene are associated with epidermolytic hyperkeratosis, and its expression is linked to the terminal differentiation of epidermal cells . CK-10 is also used as a marker for tissue differentiation and characterization of malignant tumors in surgical pathology.
Protocols
| Product Specific Protocols | |
|---|---|
| IF protocol for Cytokeratin 10 antibody 86324-1-RR | Download protocol |
| IHC protocol for Cytokeratin 10 antibody 86324-1-RR | Download protocol |
| WB protocol for Cytokeratin 10 antibody 86324-1-RR | Download protocol |
| Standard Protocols | |
|---|---|
| Click here to view our Standard Protocols |